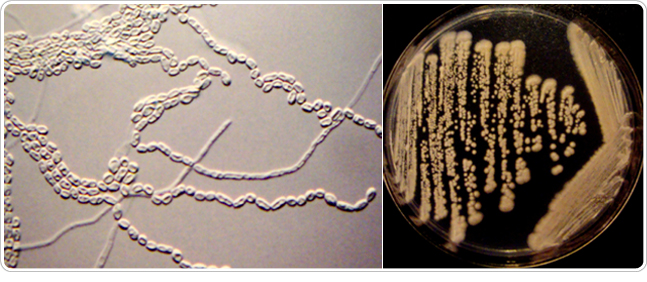

特集記事
カビ対策の決定版!~カビひと筋40年の「カビ教授」が伝授します~

梅雨は古来「黴雨(ばいう)」ともいい、じっとり蒸し暑い梅雨どきは、黴(カビ)の大繁殖シーズン。そもそもカビとは何者?病を引き起こす怖いカビって?カビの上手な防ぎ方は?身近なカビを制して、じめっとした季節をカラッと爽やかに過ごしましょう!
そもそも「カビ」って何者?〜敵か味方か、カビの意外な正体〜
ひとことで「カビ」と言っても、その正体は案外知られていません。そもそも、カビとはいったい何者なのでしょう?——人呼んで“カビ博士”ことカビ研究の第一人者、宮治誠先生に伺いました。
宮治 誠先生
1968年千葉大学大学院医学研究科卒業、医学博士。1977年千葉大学生物活性研究所教授、1997年千葉大学真菌医学センター長などを経て、2005年 株式会社ファーストラボラトリーズ代表取締役に就任。日本菌学会長、日本医真菌学会理事、アジア菌学連盟副会長などを歴任。第22回日本医真菌学会賞、第46回日本菌学会教育文化賞、第33回講談社出版文化賞科学出版賞を受賞。
カビ一筋40年!「カビ博士」の宮治先生とは?
まだ日本の医学界で誰もカビに着目していなかった40年以上前、「誰もやっていないから」という理由でカビ研究の道に飛び込んだ宮治誠博士。「誤解しないでね。私はカビを見ているだけで幸せ…なんていう“カビおたく”じゃないですからね」と笑うお茶目な先生ですが、いわく「世界中から集めたカビがぴっちぴちの生きた状態で保存されている」という日本初のカビの一大メッカ「千葉大学真菌医学センター」を担ってきたカビ研究の大御所です。
そんな先生でも、若き頃は思わぬ失敗も。教授に間違ったカビ名を報告し、「ありがとう! 世界初の症例だ!」と大喜びの教授から高級洋酒をプレゼントされ、その日のうちに友人と空に。

宮治誠先生のユニークな著作の数々。
後で間違いに気づいて慌てて報告すると、嬉々として論文を書いていた教授の目が点になった……なんて大失態もあったとか。
そんな失敗もさらなる研究ネタに、画期的なカビ研究をし続けてきた宮治先生。「カビをやってきてハッピーだった」と語る先生による“元気通信 カビ講義”をぜひお楽しみください。
カビと細菌、人間に近いのは……?
カビという呼び方は俗名で、専門的には「真菌」または「菌類」といいます。
真菌は細菌の一種と思われがちですが、実はまったく別ものです。細菌はむき出しの細胞内にDNAがある「原核生物」であるのに対し、真菌は細胞内の膜に包まれた核の中にDNAがあり、人と同じ「真核生物」なのです。つまり、カビのほうが細菌よりもはるかに進化した高等生物といえます。

ただ、細胞構造が同じため、カビに効く薬は人間の細胞にも悪影響を与えてしまいます。そのため、カビが全身にまわってしまうと治療は難しくなります。
でもご安心を!健康な人が深刻なカビの病気にかかることはまずありません。なぜなら、カビは細菌の10〜20倍も大きいため、組織や細胞に侵入することが難しく、仮に侵入できても、通常は体外に排出されるからです。ただし、病気などで免疫力が低下している場合はリスクが高まるので要注意です。
カビの種類は9万種以上もある?!
カビの種類は、現在わかっているだけでも9万7千種以上もあります。それらは「糸状菌」「キノコ」「酵母」という3タイプに分けられます。
いわゆるカビとして最もよく知られているのは糸状菌です。ミカンやお餅などに生えるカラフルなカビの多くは糸状菌と思って間違いありません。「えっキノコは違うでしょ?!」と思われるかもしれませんが、キノコもれっきとしたカビの一種です。また、浴室の壁にポツポツとできる黒いカビは酵母の一種です。パンを発酵させるイースト菌も酵母、つまりカビの仲間です。
カビの正体はエコな“掃除屋さん”?!

「カビなんて地球上から全滅すればいいのに!」——と、思う人も多いはず。でも、もし地球上のカビが全滅したら、私たちも全滅してしまいます。
なぜなら、カビは生物の不要になった有機物(毛や爪、角質、排泄物、死骸、落ち葉、朽ち木など)を、無機物に分解する性質を持っており、もしカビがいなければ、地球上はあらゆる“自然ゴミ”で埋め尽くされてしまうからです。カビがいるお陰で、地球上のゴミがうまくリサイクルされ、生態系が維持できているのです。そう、カビはエコロジーな“掃除屋さん”なのです。
人に愛されるカビとは?

チーズの製造や抗生物質の産出に利用されているアオカビ
「ぺニシリウム」
嫌われがちなカビですが、人に愛されているカビもいます。味噌、しょうゆ、日本酒、最近人気の塩麹など、日本の食文化を担う食品の多くは、実はカビを利用して作られています。ワインやビール、パン、チーズもカビの助けがないと作れません。
また、アオカビから作られるペニシリンは、抗生物質に利用されています。病気を引き起こすカビがいる一方、病気を治すのに役立つカビもいるというのが、カビの世界の奥深い所です!
皮膚や内臓に棲みつく危険なカビとは?
〜身近なカビが招くアレルギーや感染症〜
カビによる病気は、カビによって引き起こされるアレルギーと、カビそのものによる感染症に大きく分けられます(下図)。

夏風邪に似た症状に悩まされるカビアレルギー「夏型過敏性肺臓炎」
「夏型過敏性肺臓炎」のアレルゲンになるカビ「トリコスポロン」
急に痰のからんだ咳がゲホゲホ出て発熱したり、数週間も咳が止まらず息切れしたり、夏風邪のような症状がなかなか治らない場合は、「夏型過敏性肺臓炎」の可能性があります。これは夏に多い病気で、原因は「トリコスポロン」というカビの胞子を吸い込むことによるアレルギー反応です。肺炎を繰り返し、悪化すると命にかかわる危険もあります。
トリコスポロンは、日当たりが悪く湿気の多い古い木造住宅などに多く発生します。特に雨漏りや床下浸水したことのある家は、壁紙の裏など、見えない所に大繁殖していることがあるので要注意です。対策としては、常に換気をよくして湿気を防ぐことが大切です。リフォームしたとたんに症状が改善することもあります。
患者数は世界に5億人!10人に1人は「水虫」?!
世界に5億人といわれる水虫患者。水虫の原因となるのは、角質が大好物の「白癬菌」というカビ。皮膚の角質層に取りついた白癬菌は、角質を酵素で溶かしながら成長していきますが、角質は死んだ細胞なので、最初は痛くもかゆくもありません。しかし、感染が進むと白癬菌が出す酵素や老廃物が生きている細胞まで刺激するようになり、赤くなったりただれたりして、ムズがゆさを感じるようになります。

人につきやすい白癬菌「トリコフィトン・ルブルム」
治りにくいといわれる水虫ですが、治療薬を指示通り塗っていれば2週間ほどで治ります。ただ、白癬菌はお風呂場の脱衣所など、至る所にいるので、治ってもまた感染しやすいのです。しかし、白癬菌は角質についてから最短8時間で芽が出て、2〜3日で角質層に食い込むので、その前に足をよく洗えば、再発を防げます。たまに水虫を湿疹と勘違いしてステロイド軟膏を塗っている人がいますが、免疫反応が抑えられて菌が勢いづくので、さらに悪化する可能性があります。
あなたの家は、カビに愛されやすい環境?
〜梅雨どきの鉄板カビ対策10 〜
「掃除しているのにカビが減らない!」——もしかしたら、そのカビ対策に問題があるのかも?!住まいに潜むカビの撃退方法を、宮治誠先生にアドバイスしていただきました。
1.除湿機をかければ安心というのは大間違い!
カビの多くは室温25〜30℃、湿度80%以上の環境を好むので、壁や窓の結露をこまめに拭き取る習慣を。エアコンや除湿機の内部もカビが生えやすく、かえってカビを飛散させるので、フィルター清掃をお忘れなく!
2.ダニはカビの熱烈ストーカー?!
カビのいる所には必ずカビが好物のダニも繁殖しています。じゅうたん、カーペットはカビ&ダニの温床なのでこまめに掃除機をかけるのはもちろん、カビは食べこぼしが大好物なので、固く絞った水雑巾で拭きとること。
3.陰気モードから陽気モードにスイッチ!
キッチン、浴室、洗面所、トイレなどの水周りはもちろん、クローゼットや押し入れも湿気がどんよりこもりがち。換気扇や扇風機をかけてよどんだ空気を一掃し、晴れた日には窓や扉を開けて空気の総入れ替えを!
4.調理後や洗顔後にカビはウハウハ大宴会?!
キッチンにこぼれた食材や炒め物のハネもカビの格好の栄養分。調理後は要チェックを。石けんを好むカビもいるので、使った石けんやソープトレイの水分をよく拭い、排水溝にも石けんカスを残さないように!
5.ゴシゴシ磨きは逆効果?!お風呂掃除の落とし穴!
入浴後は浴槽や浴室の壁、タイルの目地の水分を拭き取る習慣を。もしカビができても、硬いブラシでゴシゴシ磨きすぎると表面に細かな傷ができ、かえってカビがつきやすくなるので、カビの部分だけ叩くように拭きとること!
6.ウラを覗いてビックリ!大きな家具の盲点
タンスや書棚を外壁側に置くと、外気との温度差で背面に結露がつきやすく、そこにカビが大繁殖する原因に! 動かして掃除しにくい家具を設置する際は、できるだけ室内の間仕切り壁側に置きましょう。
7.ショック…布団にカビ!捨てるしかない?
布団にカビが繁殖した場合は、天日干しにして表面をブラッシングすれば、日光でカビ&ダニを殺菌してダブルパンチできます。雨で干せない時は布団乾燥機の熱で殺菌を。玄関などのマット類も天日干しが有効です。
8.掃除したつもりがカビをまき散らしていた?!
掃除機をかけるとカビの胞子が吸引されてカビの繁殖を防げますが、掃除機の排気口から胞子が飛散するのでご注意を。掃除機をかける時は窓を開け、排気口をできるだけ室外に向けるようにしましょう。
9.洗濯したつもりがカビで汚していた?!
洗濯物に黒いワカメのような汚れが付着したり、不快な臭いがしたりする場合は、市販の洗濯槽クリーナーや重曹、酢、漂白剤などを使って洗濯槽のカビ掃除を。糸くずフィルターや洗剤・柔軟剤の投入ケースにもカビが生えるので、お湯で洗浄を。未使用時はフタを開けておくと湿気防止対策に。
10.毒をもって毒を制す!ただしその毒に要注意
カビを除去する際は、塩素系の漂白剤が有効です。有毒な塩素ガスを発生させることがあるので、換気に注意し、必ずマスクやゴム手袋の着用を。子供やペットがいる場合は、別の場所に避難させてください。最後に漂白剤が残らないように、有害性のない消毒用アルコールで拭き取って殺菌するのをお忘れなく!

梅干にカビが生えると、その家に不幸が起こる」という諺があります。梅干を作る過程で手抜きをするとカビが生えることから、家事全般に手抜かりがある家に幸は来ないという意味です。梅干同様、住まいにカビが生えないように、掃除はくれぐれもこまめにしましょう!
みんなの投票 あなたはどれ?
選択肢を選んで投票ボタンをクリックしてください。
あなたの一票が反映されます。

